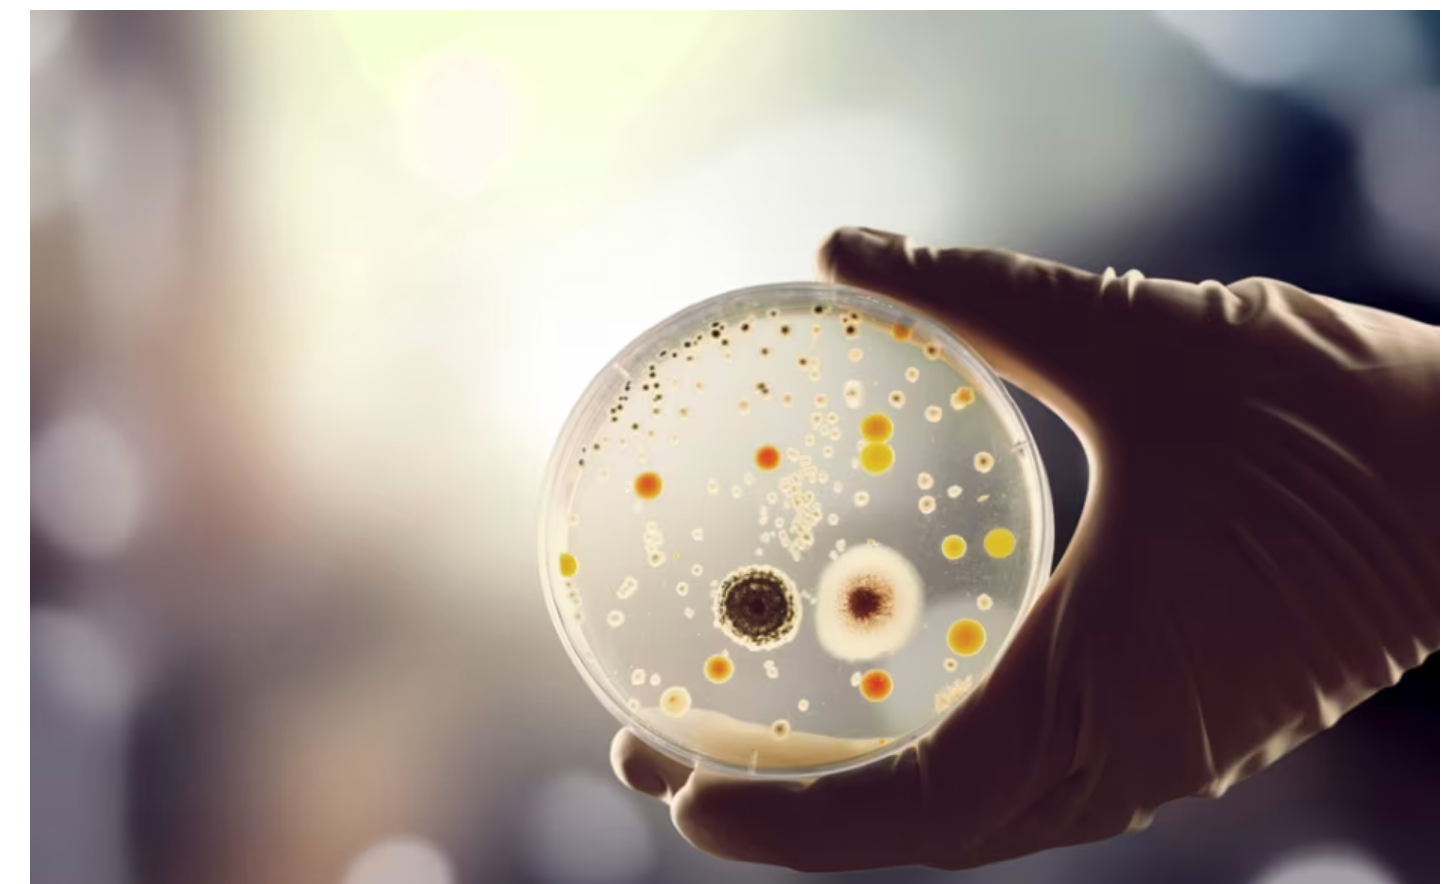

The efficacy of chitosan has been proven, but to understand how this polysaccharide works it is necessary to describe its specific characteristics and mechanism of action.
Chitosan is a natural derivative of biological origin, which is obtained starting from the partial deacetylation of chitin (a polysaccharide composed of N-acetyl-D glucosamine units) in an alkaline environment. To date, the OIV (International Organisation of Vine and Wine) allows the usage of the use of chitosan in oenology for wine processing, or to boost the activity of fining agents in both wines and musts. However only chitosan of fungal origin, and specifically from Aspergillus niger may be used in winemaking.
Research conducted in laboratory on the potential of chitosan is constantly evolving and shows surprising results; indeed, chitosan is an element which, in addition to having proven efficacy and versatility of use, also stands out because it is easily available and biodegradable.
Use and action of chitosan in musts and wines
Chitosan is a valuable support to facilitate the racking and clarification of musts. It also has an important antiseptic action by inhibiting microbiological activity.
Used in wines, chitosan promotes clarification and inhibits unwanted fermentations, which would have a negative impact on the entire process. Furthermore, it prevents the development of acetic bacteria, which are responsible for raising volatile acidity, or malolactic fermentation, where unwanted.
Another important function of chitosan is the removal of metal cations from the solution, which, reduces the content of heavy metals such as iron, lead, cadmium and copper.
On the one hand, this type of action allows avoiding copper and iron instabilities, on the other, it further destabilizes the microbial wall by removing structural cations.
In addition, it reduces any unwanted compounds such as ochratoxin A, a fungal toxin that can be found following microbial alterations in grapes. But what makes chitosan the polysaccharide of choice in oenology is its ability to inhibit Brettanomyces: against these contaminating yeasts, in fact, chitosan serves as an indispensable adjuvant and its use allows achieving incomparable results compared to other products.
The antiseptic action of chitosan against Brettanomyces
As discussed before, the most important and widespread use of chitosan in oenology relates to the inhibition of Brettanomyces, where no other adjuvant is able to perform such an effective action.
Brettanomyces is a contaminating yeast, which is particularly resistant to high levels of ethanol and can catalyse the reduction of vinylphenols through the enzyme vinylphenol reductase. This type of biocatalytic activity is responsible for the onset of olfactory defects such as the scents of “stable”, “leather” and “horse sweat”.
We need to examine the structure of chitosan in order to explain how it acts against the onset of Brettanomyces.
Indeed, we know that chitosan is obtained from the partial deacetylation of chitin, during which the release of the primary amino groups occurs, which, in an acid environment, are protonated, thus yielding a positive charge.
This particular type of charged structure is functional to the disintegration of the membranes of bacteria and yeasts. In fact, one of the mechanisms by which chitosan acts results from the fact that the outside of the cell wall for bacteria is negatively charged and, therefore, being positively charged, acts by complementary charge. On the other hand, yeasts do not have an obvious negative charge, but it is thought that they incorporate chitosan into their own wall during growth, thus leading to wall disintegration. An alternative mechanism of action can be traced back to the binding of chitosan to microbial DNA, which would effectively block DNA transcription and replication.
Chitocel, the chitosan-based AEB solution
CHITOCEL is a chitosan-based product, a natural polysaccharide of fungal origin (Aspergillus niger) which allows reducing, and, in some cases, eliminating, any unwanted microbial load in wine. It is active against acetic and lactic bacteria, yeasts in general and Brettanomyces.
The special and balanced formulation with yeast hulls allows CHITOCEL to exert a broad-spectrum antimicrobial action, thus contributing to aromatic and olfactory cleansing.
CHITOCEL is widely used in wines to be aged in wood: indeed, the porosity of wood is the ideal environment for the development and growth of microorganisms (and Brettanomyces in particular), which, although present in modest quantities, in the long-medium term can increase volatile acidity and often generate unpleasant odours.
In addition, CHITOCEL has the advantage of not belonging to the family of allergens, like other similar products that, among other things, exert an antimicrobial activity only on some families of bacteria and can contribute to increasing protein instability.
How does Chitocel work?
We explain how CHITOCEL works through a practical test carried out in the laboratory: we used a wine contaminated with Brettanomyces to evaluate the efficacy of CHITOCEL in a quantity of 5 g/hL. Even before completing a microbial count, we verified the activity of chitosan under the microscope on the contaminating yeast, and confirmed the destruction of cellular integrity.
Subsequently, in order to perform a plate count, we filtered a 50 mL aliquot of the solution on a membrane with a porosity of 0.2 µm, and then incubated it for 8 days at 30°C on a selective medium for Brettanomyces.
We observed an important difference before and after treatment with CHITOCEL: the first microbial count had such a high number of colonies that we could not quantify it. After treatment with CHITOCEL, we did not see any contaminating cells on the plate whatsoever.
A Complete Range to Reduce Sulfur
Alongside CHITOCEL we have developed other chitosan-based products, which represent excellent alternatives to SO2:
- CHITOCEL Must, which is ideal for use in white winemaking, protects the wine from early alterations, and its co-formulation with tannic acid serves as antioxidant by acting in a manner akin sulfur dioxide and can replace SO2;
- CHITOCEL Red on the other hand, is particularly suitable for the production of red wines. It allows stabilising the colour and correcting any defects; in addition, it performs the same action as sulfur dioxide thanks to the combination of chitosan and proanthocyanidin.
CHITOCEL Must and CHITOCEL Red exert a clarifying action, contribute to the reduction of the content of heavy metals such as iron, lead, cadmium and copper, thus preventing iron and copper instabilities, and allow reducing any contaminants (such as ochratoxin), thanks to the synergy with yeast hulls and tannins.
Therefore, both have antimicrobial properties and allow limiting the use of sulfur dioxide, in line with growing market demands which, in recent years, have been calling for products with ever lower sulphite contents.
The range is completed with ANTIBRETT 2.0 and CHITO-F.
ANTIBRETT 2.0 is a product combining chitosan, yeast hulls and beta-glucanase enzymes, which is particularly suitable for its inhibitory action against yeasts belonging to the Brettanomyces genus.
In fact, thanks to its antimicrobial properties, it inhibits the production of vinyl reductase, which participates in the transformation of cinnamic acids naturally present in wines, into the corresponding ethyl derivatives, responsible for the odours attributable to Brettanomyces.
ANTIBRETT 2.0 is indicated both to prevent alterations due to unwanted yeasts, and as a curative product: indeed, Brettanomyces has very long incubation times (3-8 months), during which there are no abnormal odours; therefore, its use may be required after any such odours are detected.
CHITO-F, on the other hand, is a new specific treatment based on fumaric acid and chitosan. It exerts a strong antimicrobial, bacteriocidal and bacteriostatic action, stabilizes and promotes wine clarification.
At the origin of CHITO-F is the growing trend toward natural, sulfur-free products for wine production, and a market increasingly interested in beverages with reduced sulfite contents.
Because of its potent antimicrobial action resulting from the synergy of components, it allows the use of lower amounts of SO2, protecting wines and thus representing an allergen-free alternative to stabilizers that perform the same function.
CHITO-F also plays an important role in the prevention and treatment of contamination due to lactic acid bacteria, facilitating work in the winery.
Yeast membrane fluidity:

The effect of rehydration at low temperatures on membrane fluidity:

More on AEB Yeast! www.aeb-group.com
AEB USA is pleased to introduce our new Northern California U.S. Agent - Ryan Gallagher!

Ryan Gallagher comes to us with years of technical expertise and knowledge in the wine industry. With this experience and the know-how in the winemaking sector he will provide a wide range of highly innovative biotechnological winemaking solutions that meet and exceed any production need!
Please reach out to Ryan Gallagher in your area: rgallagher@aeb-group.com
AEB ENGINEERING: A complete range for any winemaking need
Our equipment for wine production and treatment constitutes a complete proposal capable of satisfying all types of wineries, whatever their production capacity. We have specific plants to optimize the dosing of adjuvants, ensuring high precision of use and maximum safety.
For many years now we've also facilitated the management of alcoholic fermentation, starting with the proper reactivation and acclimatization of dry yeasts thanks to our REACTIVATEUR 60 line.
The equipment for accurate dosing of adjuvants
AEB ENGINEERING plants ensure safe, consistent and accurate dosing of nutrients, clarifiers, tannins, enzymes, sulfiting agents and adjuvants.
During mechanized harvesting, the use of DOSANOXIT T allows the distribution of liquid sulfiting agents and antioxidants. In the early stages of grape processing, DOSAPROP HI-FLOW allows in-line additions of liquid adjuvants in proportion to the flow and ensures perfect homogenization. Our proposal is completed with the DOSER FOR AUTOCLAVES, specifically for the transfer and injection of already dissolved products in pressurized (and non-pressurized) circuits up to 7 Bar.

The smooth course of the fermentation process is a crucial step and is mainly related to obtaining the prevalence of selected yeasts. This is possible thanks to REACTIVATEUR 60, a line of specific plants for reactivation and acclimatization of yeasts. These plants help improve fermentation kinetics even under less than ideal conditions and can be used to reactivate stuck fermentations. New this year is REACTIVATEUR 60/300, which allows the rehydration of small amounts of ADY, from 0.5 to 5 kg.
The success of FA also comes from the constant additions of nutrients and adjuvants in an automatic and programmed manner. This is why we designed CTRL-TANK, which can dose up to 3 different products simultaneously and/or separately into 5 tanks, with the ability to schedule additions over time and manage operations remotely.
ISIOX- SYSTEM FOR THE MANAGEMENT OF GASES DISSOLVED IN WINE
ISIOX is designed to optimize the various low molecular weight gases dissolved in wine in a simple, non-invasive way, with automatic and semi-automatic modes of operation. It allows standardized results and bottle shelf-life improvement.

Focus on Stabilization
ISIOX application allows to alter oxygen and carbon dioxide levels as well as remove hydrogen sulfide and methyl mercaptan. The system is beneficial and optimal for regulating gas concentration during the final stages of wine stabilization such as racking, transportation, refrigeration, or filtration and especially during bottling, without stripping. Through olfactory cleansing and elimination of light sulfurous compounds, ISIOX makes it possible to improve the organoleptic quality of the wine, adapting it to the tastes of the target market. The range of ISIOX over the years evolved adapting its characteristics more and more to the specific processing needs of customers.
Method

ISIOX technology enables the regulation of dissolved gases at the molecular level. The treated wine flows through a hydrophobic molecular sieve in counterflow to the technical process gas. The partial pressure difference results in the subtraction or addition of low molecular weight gases dissolved in the product. The system thereby provides the best alternative to stripping, preventing losses in aroma.
The main practical applications of ISIOX®
- Remove oxygen during racking, unloading of road tanks, after tartaric stabilization or after a filtration (also before the bottling) to improve the shelf life of wines.
- Remove, maintain or add CO2 until 12 g/l (6 bars) to modify the gustative impact according to the customers preferences or the typical tastes of markets (- CO2 = + sweetness; + CO2 = + liveliness).
- Remove the hydrogen sulfide (even if it is under the olfactive threshold) to prevent or eliminate the reduction phenomena and have a better olfactive cleanliness, also after the prise de mousse.
- Regulate CO2 pressure of sparkling wines up to 6 bars either to have a precise and homogeneous datum for all bottles, or to avoid the bottle explosion.
- Remove CO2 before the filling of flexible containers (BiB and Tetra Pack) to avoid deformation.
Benefits
- Processing of all types of wine
- Simple to use via user-friendly and intuitive interface
- Rapid integration into production lines
- Automatic and semi-automatic modes of operation
- Display of status parameters and alarms
- Reproducibility of the operating cycle and standardized results
- Automatic adjustments to flow rate fluctuations
- Castors for transportation
- Made in Italy
Range
MODEL FLOW RATE MAX (HL/hour)
ISIOX 1 TECH UP TO 60
ISIOX 2 TECH UP TO 120
ISIOX 500 TECH UP TO 500
ISIOX 1 LOGIC UP TO 60
ISIOX 2 LOGIC UP TO 120
ISIOX 3 LOGIC UP TO 180
ISIOX 4 LOGIC UP TO 240
ISIOX 5 LOGIC UP TO 300
ISIOX 500 LOGIC UP TO 500
* The LOGIC models provide for the measurement of dissolved oxygen and its automatic management. The automatic management of carbon dioxide, also for LOGIC models, is optional.
ISIOX PROVIDES HIGHEST STANDARDS OF SUSTAINABILITY
Social Sustainability
Reduction in the use of sulfur dioxide to facilitate the production of healthy wines
Economic Sustainability
Replacement of the most time-consuming manual processes
Reduction in operation times via automation
Reduction in electricity consumption (200-400 watt/h)
Reduction in technical gas consumption (nitrogen) as compared to stripping
Environmental Sustainability
Reduction in water consumption
Long service life
Reduction in the need for spare parts and consequent disposal thereof
Storing a dry sieve with no need for chemical sanitizers
Has a strong Antimicrobial action and will stabilize and promote wine clarification
CHITO-F: A BALANCED BLEND OF CHITOSAN AND FUMARIC ACID
At the origin of CHITO-F is the growing orientation towards natural, sulfur-free products for vinification and a market increasingly interested in drinks with reduced sulfite content. From the latest studies of our R&D department comes a new specific treatment based on fumaric acid and chitosan.
Chitosan is a natural derivative of biological origin that is obtained by partial deacetylation in an alkaline environment of chitin, a polysaccharide composed of n-acetyl-d glucosamine units. The chitosan permitted for use in oenology must in fact be of fungal origin, from fermentation of Aspergillus niger.
Fumaric acid is an acid naturally occurring in fruit and vegetables and has been isolated in the roots of the wild herbaceous plant Fumaria officinalis (Fumariaceae) from which it derives its name. Fumarate, the anionic form, is an intermediate in the citric acid cycle and is formed by the oxidation of succinate. The fumarate is then converted by fumarase to malate.
HOW TO REDUCE SULPHUR DIOXIDE WITH CHITO-F
CHITO-F exerts an antimicrobial, bactericidal, bacteriostatic and stabilizing action and promotes wine clarification. Thanks to its powerful antimicrobial action resulting from the synergy of its components, it allows for the use of less SO2, protecting wines and thus representing an allergen-free alternative to stabilizers that perform the same function.
CHITO-F also plays an important role in the prevention and treatment of lactic acid bacteria contamination, facilitating work in the cellar. It also avoids spontaneous malolactic fermentation of malic acid, favoring an antiseptic action that guarantees the absence of biogenic amines from unselected microorganisms. This product also does not interfere with polyphenols, preserving the color of the wine.
After the addition of CHITO-F, the wines are clean on the nose and free from olfactory deviations of bacterial origin. Treated wines also show a natural freshness. CHITO-F can be used in aged red, white and rosé wines.

Microbiological Stability Sulfite Reduction Allergen-free Alternative Reduction of Biogenic Amines

Freshness and Cleanliness
For your wine we want the best: that's why we have a complete range of enzymes designed to enhance and complement what is already naturally present in the grapes. Each of our enzymes responds to precise needs and solves the problems that may occur during the winemaking process in a short time.
Why is it important to choose the right enzyme?
Enzymes are proteins present both in the skin and in the pulp (pectinases and glycosidases), which speed up the vinification process. They act by lowering the reactions activation energy at different stages of the process and each enzyme affects specific substrates: that’s why it is very important to choose the right enzyme. Our enzymatic preparations are the result of extensive research and combine a mix of activities aimed at guaranteeing each winemaker the desired result.
AEB Enzymes: A Complete range for every need!
All our enzymes, available both in micro granulated and liquid form, are ready to use and easy to use throughout the entire production process:
- Aromatic expression Enzymes: separate the terpene from glucose to make the compounds volatile, thus helping to improve aromatic expression.
- Clarification Enzymes: degrade pectins and speed up the clarification of the must.
- Maceration Enzymes: allow a greater extraction of color, thus reducing maceration time.
- Maturation Enzymes: are ideal to obtain a rounder and more complex wine thanks to the release of aromas and mannoproteins during the aging phase.
- Microbiological stability Enzymes: are added to the wine to prevent new malolactic fermentation to guarantee greater freshness.